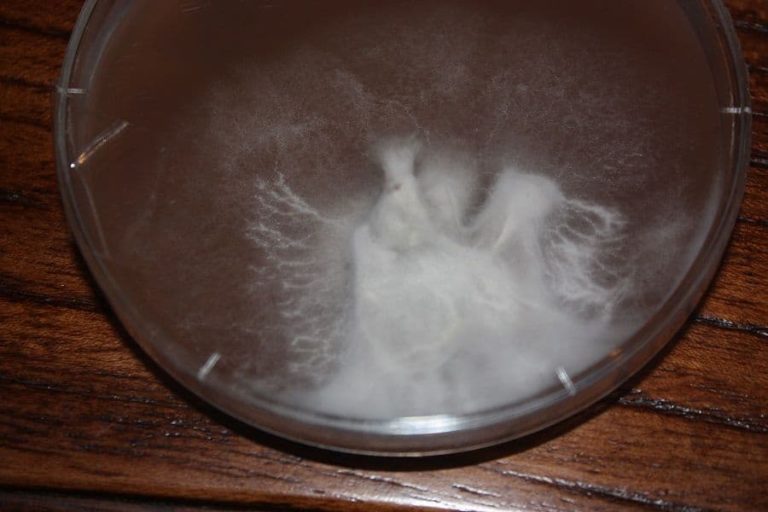

Selby Shroom’s favourite mushroom – the wood blewit is an magnificent looking species with lilac gills, a meaty mottled lilac stem, a strong margin and a viscid lilac to brown cap. In Selby this mushroom can appear solitary or in large patches below dogwood, Messmate stringybark forest where it appears with a very brown cap, or under pine trees where it seems to produce a milder cap colour and less distinct fruity odour. Some seasons they barely appear at all; other years they appear in abundance. They are a late winter mushroom – seeming to flush when the others are winding down in June/July once cold frosts start.
This mushroom’s perfumey, fruity, orange-juicy aroma is always amazing. It is a mushroom that is second to none in terms of the strength of its rich, earthy flavour. While some believe it is an acquired taste and that it tends to dominate most dishes, it is still a very versatile mushroom. Some report mild allergic reactions to this mushroom and it should never be eaten uncooked.
DNA sequencing of our local Lepista nuda place them at 100% Japanese and European nuda.
We specialise in collecting this mushroom in the wild – in fact the largest single collection of this mushroom occurred in our backyard in 2011 under a large messmate!
Our price this season for this mushroom is $40-$50 per kilo depending on local yields. We also intend to sell 2.5 litre spawn bags of this mushroom for $40 each and petri dish cultures for $25.
Selby Shrooms taste rating for this species: Excellent

Picked 3 kilos today around my bowling green they grow around compasting fine grass cuttings I’m at Cudworth Nr Barnsley
I did see someone was finding nuda up near Sydney which is very unusual for this time of year. Lepista sordida is often the species more commonly associated with grass cuttings.
Do these fruit under cedrus deodar – are there any other mushies that might look/feel/smell like these ones?
Sure the definitely do – one of many species I find them under. My best spot weirdly is a Monkey Puzzle Tree. The main species that can cause confusion is purple native Cortinarius like Cortinarius archeri.